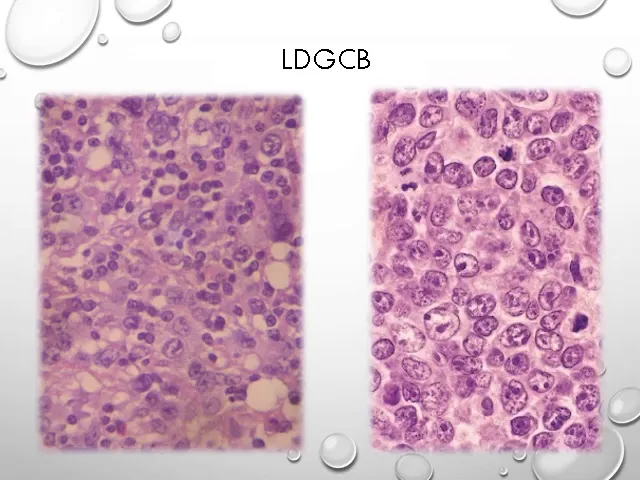

una forma muy frecuente en el adulto es el linfoma folicular y como su nombre lo indica surge de los folículos linfoides ve corresponde al 40 por ciento de los linfomas no-hodgkin y eso le informa de tipo en general indolente pero por supuesto también incurable ocurre en pacientes adultos mayores de 50 años y es muy común que al momento del diagnóstico lenta lo encontremos en un estadio avanzado como vemos en la imagen si bien es indolente en un 30 por ciento de los casos puede adquirir mutaciones que los llevan a transformarse en un linfoma agresivo que
es el informa difuso de grandes células de donde surge este linfoma folicular obviamente del centro germinal el origen es un linfocito centro germinal cd20 positivo porque es sede 10 positivo que marca un origen del centro germinal que tiene muchas veces alterado el bcl6 pero más habitualmente tiene alterado el be zeledón se acuerdan anti apoptóticos el linfoma folicular como habíamos visto anteriormente tenía una translocación característica esta translocación entre el cromosoma 14 nuestro conocido de la cadena pesada y la inmunoglobulina y el 18 yuxtapone al bc de 2 que estaba en el 18 junto al locus de
la inmunoglobulina haciendo que se sobreexpresa el bcl2 el anti apoptóticos por excelencia y genere una proliferación y supervivencia de estas células también se agregan otras alteraciones epigenéticas este linfoma folicular cuando lo observamos en el ganglio linfático tiene una característica de nódulos en su patrón architectural y cuando lo observamos el aspecto de la citología básicamente predominan unas células pequeñas centros foliculares a las cuales llamamos en trocitos que tienen un núcleo privado y escasas células un poco más grande con núcleo los en sus membranas 3 por lo menos núcleos los pegados en sus membranas que son los
centros blastos el centro citó para que recordemos un poco es la célula que predomina en la zona clara del centro germinal habitualmente y el centro blast o es la sole la célula que predomina en la zona oscura normalmente del centro germinal como dijimos hoy son ve con lo cual son cd20 positivos el pse de 10 es un marcador de centro germinal y teníamos sobre expresado el bc de 2 en los casos en que se tornó más agresivo va a ver sobre expresión del bcn 6 el grupo más importante de linfomas agresivos o más frecuentes son
los informas difusos de grandes en las de también con origen muchos de ellos no todos en el centro germinal ocurren también en el adulto en personas mayores de 60 años y su localización frecuente es el anillo de walt de hielo sea la cavidad búscalo la cavidad oral su origen como vemos en la imagen está también en unifoz y tobe centro germinal pero ahora único sito que estaba en la zona gris el centro blanco este centro blast o es de 20 positivo porque es bs ve bien porque centro germinal y tiene sobreexpresada el bcn 6 se
acuerdan esa gente que era permisivo para la proliferación y que se pueda hacer la hiper mutación somática dentro del centro germinal los linfomas difusos de grandes células pueden originarse de nuevo a partir de estas células o ser una tramite por ejemplo el linfoma folicular o una leaf leucemia de linfocitos pequeños el leucemia linfocítica crónica esto sin formas de difusos de grandes se las ve en general nos encontramos en un estadio muy avanzado como vemos en la imagen lo podemos dividir actualmente en dos grupos en base a la expresión de sus genes hay algunos que tienen
una alta expresión de genes de tipo centro germinal comúnmente presentan el bcl2 y en este caso tienen una mayor supervivencia de estos pacientes o sea no son tan agresivos otro grupo tiene un patrón genético desde las ve activadas periféricas y ellos le llamamos a veces genéticamente podemos ver diversas alteraciones mayormente en las alteraciones del bcn 6 que lo que hacen es el bcl6 inhibida la provisión pero si lo tenemos alterado lo que hace es permitir la proliferación en ese estado de ese lado y centro blast o cuando aparecen a su vez otras alteraciones en otros
géneros como el p53 o en el 'mix' eso habla de un linfoma que tiene peor pronóstico y también se suman muchas alteraciones epigenéticas en el tórax y lógicamente este el informa de grandes son las difusos lo podemos ver sobre todo el que tiene el patrón de centro germinal donde la mayoría de las células son de tipo centro blast o esas células grandes que tenían varios núcleos en sus membranas o el patrón a veces tener células del info blastos activado donde vemos en las grandes con un núcleo lo prominente central al que llamábamos inmuno blast inmundo
plástico obviamente estos son linfomas con alta proliferación y fíjense en acá en la imagen podemos ver varias mitosis en ser las atípicas el informe de burkitt es otro linfoma de un linfoma ve que también sale del centro germinal de un plato germinal es altamente agresivo y tiene un alto índice de proliferación histológica linfoma de burkitt tiene distintos tipos y variantes clínicas y obviamente su evolución va a depender de esta variante inicialmente fue diagnosticado en la forma de pi del ica asociado al estándar virus como vimos anteriormente en niños en áfrica ecuatoriana y su localización habitual
era en mandíbula las variantes de el informe de burkitt que vemos en occidente son la variante esporádica que ocurre en gente joven y que no estás siempre asociables está en barbie lo podemos encontrar no sólo en un 15 al 30 por ciento y en ninguno deprimidos también vemos una variante de informa de burkitt donde entre un 30 y un 40 por ciento de los casos se asocia al externar virus el origen como vemos en la imagen es un vasto centro folicular que va a ser sede 20 positivo como estirpe sede 10 positivo porque es el
centro folicular y tiene la alteración del bcl6 lo que habla que sale de la zona gris el linfoma de burkitt habíamos visto que tiene una translocación característica entre el cromosoma 8 y el 14 y que hace que el gen mic se tras lo que en general al lado de nuestro gen conocido el gen de la cadena pasada la inmunoglobulina lo que genere una sobreexpresión del mic ahora esa es la principal tras locación que nosotros observamos pero puede verse también que haya otro tipo de traslocaciones que este gen mikel vez de ponerse al lado del gen
de la cadena pesada lo hago acá al lado de el gen de que la cadena liviana capa en el cromosoma 2 o que lo haga al lado del gel de la cadena liviana lambda en el cromosoma 22 cualquiera de estas tres locaciones son marcadores del linfoma de burkitt básicamente lo que ocurre es la sobreexpresión del lic recordemos que el mic era muy estimulante de la proliferación por eso lo que observamos teológicamente es una gran proliferación de blastos que por supuesto también como ustedes están viendo ahí esos espacios claros corresponden a macrófagos que están fagocitando las
células que pueden ir hacia la apoptosis ósea donde muchas proliferación también hay muchas apoptosis entonces ese aspecto de ser las claras que aparece en una proliferación de muchas células se llama cielo estrellado básicamente habla del índice de proliferación

![S&P500 to Break Record High Soon! (Livestream Alert for Tonight!) [Global News]](https://img.youtube.com/vi/AYRF3r2wGjc/maxresdefault.jpg)




![Goodness! Not Again! [Global News]](https://img.youtube.com/vi/4qbir5n3eMk/maxresdefault.jpg)

![[FULL] PM Lawrence Wong announces Cabinet reshuffle following GE2025 | Press conference](https://img.youtube.com/vi/Nsk1t1gHljk/maxresdefault.jpg)

